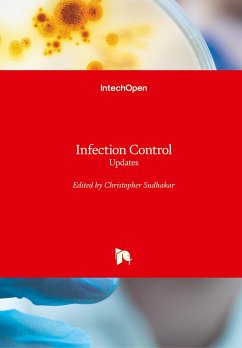
Cover Infection Control

Infection Control
A Psychosocial Approach to Changing Practice
Versandkostenfrei!
Versandfertig in 1-2 Wochen
54,99 €
inkl. MwSt.
Weitere Ausgaben:

PAYBACK Punkte
27 °P sammeln!
Paul Elliott has drawn together a thought-provoking collection of topics that together explain the psychology of infection prevention and control. This is a book about how to change and improve practice, written by people who understand the trade of infection prevention and control. Reflection exercises are cleverly used throughout the text to provoke the reader to think of their own experiences in and their practice of healthcare. The reader is led into considering how improvements can be made to the delivery of infection prevention and control, and at the same time to understand why the way ...
Paul Elliott has drawn together a thought-provoking collection of topics that together explain the psychology of infection prevention and control. This is a book about how to change and improve practice, written by people who understand the trade of infection prevention and control. Reflection exercises are cleverly used throughout the text to provoke the reader to think of their own experiences in and their practice of healthcare. The reader is led into considering how improvements can be made to the delivery of infection prevention and control, and at the same time to understand why the way we think ultimately determines the likelihood of their success. Each reflection exercise is accompanied by clear and concise explanations, helping the reader to analyse and critique him/ herself and the way we do things now.